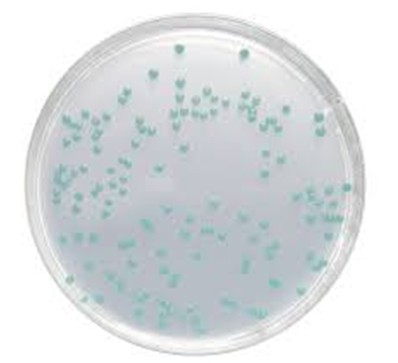

Chất Phụ Gia ChromoCult Listeria Agar Enrichment-Supplement 100439 Merck
Mã sản phẩm: 100439
Thương hiệu: Merck – Đức
Xuất xứ: Đức
Chất Phụ Gia ChromoCult Listeria Agar Enrichment-Supplement 100439 Merck là dung dịch huyền phù L-α-phosphatidylinositol vô trùng được sử dụng với môi trường cơ bản để chuẩn bị Chromocult® Listeria Selective Agar nhằm phát hiện chọn lọc và phân biệt các loài Listeria spp. trong thực phẩm và đồ uống. Các đặc điểm chính của sản phẩm bao gồm tính phù hợp cho thử nghiệm tác nhân gây bệnh, sử dụng trong các phương pháp tuân thủ ISO, và chức năng phân biệt L. monocytogenes và L. ivanovii thông qua việc hình thành một quầng mờ đục xung quanh khuẩn lạc của chúng do quá trình thủy phân phosphatidylinositol.
- Mô tả
Mô tả
Chất Phụ Gia ChromoCult Listeria Agar Enrichment-Supplement 100439 Merck
Chất Phụ Gia ChromoCult Listeria Agar Enrichment-Supplement 100439 Merck (MilliporeSigma) là hỗn dịch vô trùng của L-α-phosphatidylinositol, được sử dụng để phân biệt Listeria monocytogenes với các loài Listeria khác khi được thêm vào môi trường thạch thích hợp.
Chi tiết sản phẩm Chất Phụ Gia ChromoCult Listeria Agar Enrichment-Supplement 100439 Merck
- Chức năng: Sản phẩm này là một chất phụ gia dùng để pha chế thạch nền, cụ thể là ChromoCult® Listeria Agar (base) theo Ottaviani và Agosti (mã sản phẩm 100427), được sử dụng để nuôi cấy chọn lọc và phân biệt các loài Listeria spp.
- Cơ chế hoạt động: Bổ sung này cho phép phân biệt Listeria monocytogenes thông qua việc phát hiện một loại enzyme đặc hiệu, phosphatidylinositol-specific phospholipase C (PI-PLC). Listeria monocytogenes thủy phân chất nền tinh khiết trong chất bổ sung, tạo ra một quầng mờ đục xung quanh các khuẩn lạc của nó trên thạch.
- Thành phần: Đây là hỗn dịch đồng nhất, vô trùng của L-α-phosphatidylinositol trong nước cất.
- Bao bì: Sản phẩm có mã số đặt hàng 1.00439.0010 và thường được cung cấp dưới dạng 10 lọ mỗi hộp, mỗi lọ đủ để pha 500 ml môi trường.
- Tiêu chuẩn: Môi trường được pha chế với chất bổ sung này tuân thủ các tiêu chuẩn quốc tế về phát hiện và định lượng Listeria monocytogenes trong các mẫu thực phẩm, thức ăn chăn nuôi và môi trường, chẳng hạn như EN ISO 11290-1 và EN ISO 11290-2.
- Sản phẩm liên quan: Để chuẩn bị môi trường chọn lọc hoàn chỉnh, phải sử dụng kết hợp với ChromoCult® Listeria Agar Selective-Supplement (mã sản phẩm 100432), có chứa hỗn hợp kháng sinh để ức chế sự phát triển của vi khuẩn đi kèm (Amphotericin B, Polymyxin B, axit Nalidixic và Ceftazidime).